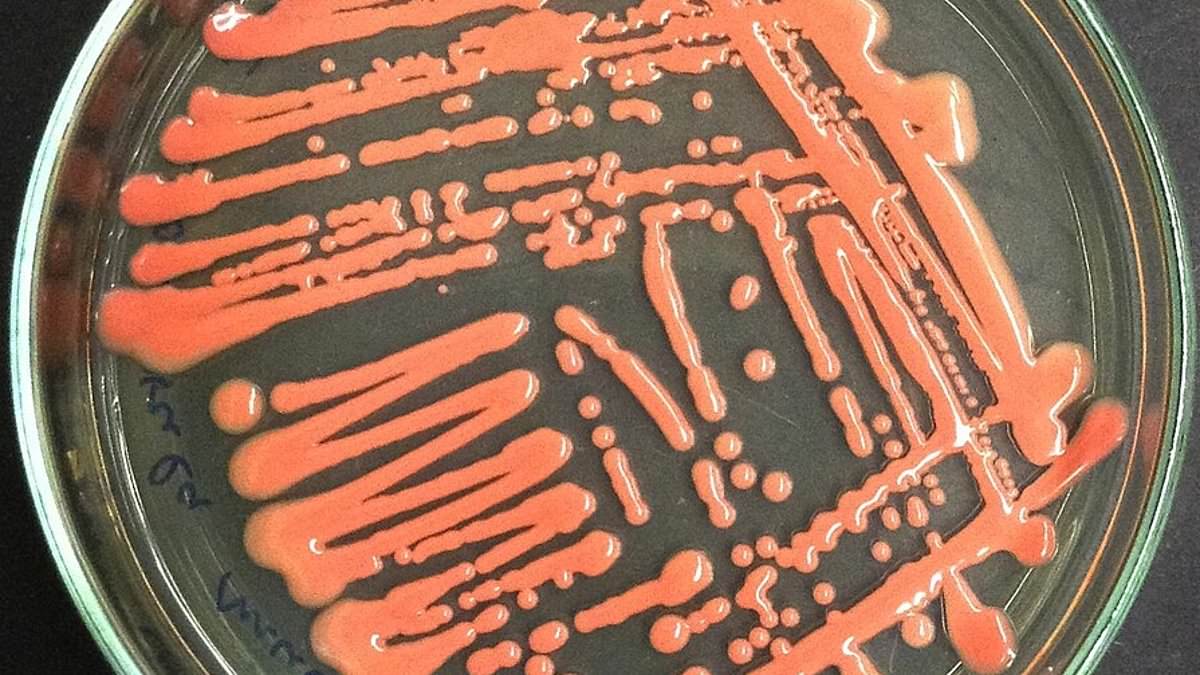
DailyMail's tweet image. Never-before-seen fungus that mutates at 'hyper' speed is discovered in China as two patients die with it trib.al/t70q0xe

#mutating search results
Detecting rapidly #mutating #bacteria and #viruses with #AutoPLP. phys.org/news/2023-02-r…

A #Catastrophic #Mutating event Will #Strike the #World in 2 Years, Report Says. #Whale meat #vending #machine business continues #boom in #Japan

Very unwelcome news! H5N1 genotype D1.1 6 identified in 6 Nevada dairy herds. This is NOT the strain that's been circulating on farms so far. It's the strain that sent a 13yo girl in Canada to ICU, and that killed a man in Louisiana. Bad time for a public health comms blackout.

When I listen to music these days, I hear strange sounds & voices that are #negative in the music, I have in my library. When I pause, playback stops although I hear a #human voice leaving commitment to #mutating my #music. These people are probably the #machines in the #Matrix.
It seems like a #performance - and the guy actually never says what they say he does; what he does say is still incriminating. Not proof that #bigpharma is #mutating #Covid. None the less this video is enough to give pause. Do you think this is real?
Very unwelcome news! H5N1 genotype D1.1 6 identified in 6 Nevada dairy herds. This is NOT the strain that's been circulating on farms so far. It's the strain that sent a 13yo girl in Canada to ICU, and that killed a man in Louisiana. Bad time for a public health comms blackout.

#Pfizer Exploring "#Mutating" #COVID #Virus For #New #Vaccines: Project #Veritas #directed #Evolution rumble.com/v279e00-pfizer…
the video has been taken down, but a #Pfizer employee admitted on a hidden camera belonging to #projectveritas that Pfizer is #mutating the #Covid virus in very dangerous ways.
It’s really interesting how #Pfizer is trying to mutate the Covid virus and now the company is trying to cover it up. youtu.be/u5n7RRKgDog
If you believe that #covid19 is ancient history, please @Google BA.2.86 EG.5 The #Flu will disappear long before the continually #Mutating SARS-CoV-2 #Virus. nebraskamed.com/COVID/what-cov…
#Pfizer Considering ‘#Mutating’ Covid-19 Virus for New #Vaccine Opportunities 😠 thedcpatriot.com/breaking%f0%9f…
2/2 Ming Yeh et al have demonstrated how #mutating the oral polio #vaccine (OPV) strain can genetically stabilise the strain and take charge of #evolutionary dynamics in Yeh et al. Genetic stabilization of attenuated oral vaccines against poliovirus types 1 and 3. Nature, 2023
#RealityCheck: #covid19 is still here, and continually #Mutating. #Ontario had more SARS-CoV-2 #Infections in #2022 than during #2020 or #2021.
"We had more people die in 2022 in Ontario than in 2020 or in 2021 from COVID... an infection prevented is for the best of all of us." — @DrFahadRazak (@UnityHealthTO) at 8/11pm with Jennifer Frontera (@nyulangone), @deonandan (@uOttawaHealthSc) & @spaikin | Producer: @ebombicino
#PROOF: #Vaxx is #MUTATING #children: #GeneticPatterns Changed By #Bioweapon #Jab bit.ly/3XPX5vc
"We had more people die in 2022 in Ontario than in 2020 or in 2021 from COVID... an infection prevented is for the best of all of us." — @DrFahadRazak (@UnityHealthTO) at 8/11pm with Jennifer Frontera (@nyulangone), @deonandan (@uOttawaHealthSc) & @spaikin | Producer: @ebombicino
#PROOF: #Vaxx is #MUTATING #children: #GeneticPatterns Changed By #Bioweapon #Jab bit.ly/3XPX5vc
Nothing to see here folks... Just a @pfizer employee talking about "#mutating" #COVID19 #virus... What could go wrong? Another #win for the #ConspiracyTheorists and another loss for #BigPharma #BigTech & @CDCgov Trust is completely lost! #ProjectVeritas
BREAKING: @Pfizer Exploring "Mutating" COVID-19 Virus For New Vaccines "Don't tell anyone this...There is a risk...have to be very controlled to make sure this virus you mutate doesn't create something...the way that the virus started in Wuhan, to be honest." #DirectedEvolution
The #Mutating #Virus: Understanding #Antisemitism. "The hate that #begins with #Jews #never #ends with Jews." Rabbi Jonathan Sacks youtu.be/uwN1WuDwIf0?si…

youtube.com
YouTube
The Mutating Virus: Understanding Antisemitism | Rabbi Jonathan Sacks
woke up and my hair was curly today for the first time ever in my life #mutating genetically 😳
Potentially #mutating #bat #virus has some scientists worried about the next #pandemic ... | #merbecovirus | #HKU5 | #ACE2 | #MERS | By @jklawanswrites.bsky.social via @theweek.com buff.ly/IJ0Z4Om
As the respiratory #virus is #mutating & changing its genes, #animal-to-human #transmission becomes more common. @JohnsHopkinsSPH @andrewpekosz explains that there have been-as of May-80 human cases of #avian flu reported in the U.S. in the past 12 months healio.com/news/rheumatol…
healio.com
It starts with animals: Health care providers must be ‘alert’ to avian flu warning signs
Growing up in rural Indiana, I had more animal friends than human ones. I raised ducks and geese, and enjoyed my time surrounded by nature. I found animals to be better listeners, and I felt calmed...
You aren’t much of a “Dr” if you’re not looking globally about what’s already happening. #H5N1 is rapidly #mutating. RT nature.com/articles/d4158…
nature.com
Will bird flu spark a human pandemic? Scientists say the risk is rising
Nature - H5N1 is adapting to new mammalian hosts, raising the possibility of the virus spreading between humans.
Very unwelcome news! H5N1 genotype D1.1 6 identified in 6 Nevada dairy herds. This is NOT the strain that's been circulating on farms so far. It's the strain that sent a 13yo girl in Canada to ICU, and that killed a man in Louisiana. Bad time for a public health comms blackout.


The USDA’s recent findings are concerning 🧵 H5N1 samples from dairy cows in California and swine in Oregon have revealed the virus is not only infecting unexpected mammalian hosts. It’s also mutating in ways that should set off alarms. 1/

Never-before-seen fungus that mutates at 'hyper' speed is discovered in China as two patients die with it trib.al/t70q0xe
#Covid is still present in our society, deaths are still surging and from time to time the virus keeps #mutating while the #elite and the #Rothschilds wait with anxiety and pleasure how many people it will #kill this time It are the #zionist #Rothschilds x.com/TRyanGregory/s…
Dr. Mark Holland: The Covid Vaccine is a never ending injection and a miracle of science, don't wait they're fun and good for you 😊 #Mutating

Worrying signs as monkeypox virus mutates | “Surveillance needs to be global if MPXV is to be eliminated from the human population and then prevented from reemerging.” #mpox #mutating #vax #protect theeastafrican.co.ke/tea/science-he…
Monkeypox virus mutating, posing new threats to public health – study - The Jerusalem Post #mpox #mutating jpost.com/health-and-wel…
jpost.com
Monkeypox virus mutating, posing new threats to public health – study
The monkeypox virus was once only spreadable from rats to humans but, with prolonged exposure to the human immune system, new strains have become more viral than ever before
Covid news live: New variant Pirola in UK - seven symptoms to look out for | Express.co.uk #covid #pirola #mutating express.co.uk/life-style/hea…
ಅರಣ್ಯ ಇಲಾಖೆ ಭೂಮಿ ಪರಿವರ್ತನೆ: ಇಬ್ಬರು ಕೆಎಎಸ್ ಅಧಿಕಾರಿಗಳ ವಿರುದ್ಧ ಎಫ್ಐಆರ್ ದಾಖಲು FIR against KAS officers for mutating, selling forest land in Bengaluru #FIR #KASofficers #mutating #Bengaluru #Land #ಎಫ್ಐಆರ್ #ಕೆಎಎಸ್ಅಧಿಕಾರಿ #ಭೂಪರಿವರ್ತನೆ #ಬೆಂಗಳೂರು #ಭೂಮಿ @XpressBengaluru Read more here:
The public mint is now live 🔥 Get your @NIGHTBREAKERZ_ mutating NFTs now on mintit.studio #nfts #halloween #mutating #kda

🤔 So, if it #mutating this rapidly then immunization is a waste of efforts and resources. 🤔🙄 And the #allegedly "#reported" #symptoms of #vaccine are similar to mini #stroke. The nurse in #Tennessee and #Beals syndrome.

Interesting that we learn from the @NFL that #COVID19 is #mutating. From a statement released by Baltimore @Ravens team President #DickCass they announced they have at least "4 unique strains of #COVID19" in their facility. One "much more contagious" than the others. Crazy.

How gross is that? Now do u ppl believe me when I say I'm allergic to cats & dogs? I'm #mutating ☹ yfrog.com/odwipkrj
Our Mad Scientist went add it again. This time he experimented on Crotts. We are glad the Scientists knows what he is doing kinda....you always hope for the best. What do you guys think? Let us know 👇 #gen2iscoming #mutating

Shit's gettin serious!😱💯💩 WTF is my life??!! ... #XMan #Mutating #BurningBush #Mystery #GenomesProject @RareRevolutionM @rarediseaseuk @GeneticDisUK @GeneticAll_UK @Cardiomyopathy

L'Officiel Art // #Mutating Mexico - Con vistas de @_pedroreyes y @longdrivesouth #locals @mariaholley @marioballe

New routine kicking my butt, today an hour HIIT outside the hour of weights...#beasting #IAmNotDoneYet #mutating

I want this #lockdown continues, until we have completely beaten this #mutating #COVID19. I just want all the fellow people of the world to feel #SAFe again. This is not about mother #Earth healing itself it about the best creations of #MotherEarth feeling threatened.

I’m ready to start #Mutating my #LeftoverZ 💩 I’ve got me 6 of those arcades 💪🏼

Evolved Leftoverz might be coming sooner then you think. 573 in total

Effects of #Mutating Trp42 #Residue on γD-Crystallin Stability pubs.acs.org/doi/10.1021/ac… #Current_issue #Computational_biochemistry

#Seagulls are apparently #Mutating they are forming the #PecksMen #MondayThoughts hide your baby's and pets!!

Something went wrong.
Something went wrong.
United States Trends
- 1. #SummerHouse N/A
- 2. Ciara N/A
- 3. NATO N/A
- 4. Kristi Noem N/A
- 5. Happy Trans Day of Visibility N/A
- 6. April Fools N/A
- 7. Doc Rivers N/A
- 8. Amanda N/A
- 9. Corey N/A
- 10. NPR and PBS N/A
- 11. #Supergirl N/A
- 12. LGBTQ N/A
- 13. Vrabel N/A
- 14. Shelly Kittleson N/A
- 15. Supreme Court N/A
- 16. #WEWILL_NEVER_GIVEUP_ON_ENHA_7 N/A
- 17. Ivey N/A
- 18. Baghdad N/A
- 19. Backrooms N/A
- 20. Amare N/A























































































